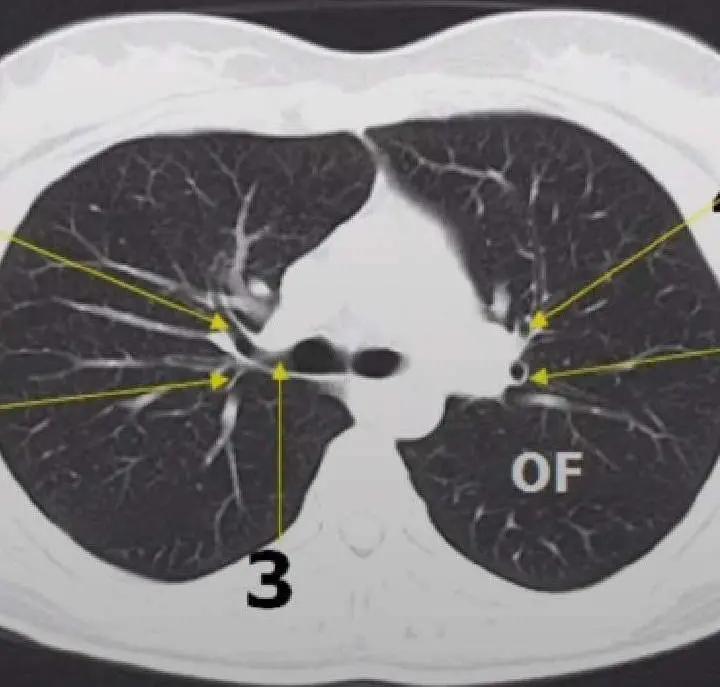
中国第一例肺移植病人,哪个医院能肺移植

烟龄30年的老王
一直患有慢阻肺
合并肺大疱
常年胸闷气短

3周前
正在干活的他
突然觉得胸部“砰砰砰….”
像什么炸了

随即立刻感觉胸闷、气喘,
不能呼吸

120迅速将他送到当地医院
CT显示“气胸”——
老王的“肺泡破了”

医生立即穿刺引流
老王感觉瞬间轻松
1周后放心地出院了
聪明的你肯定想到了
事情并没有那么简单
没过2周
老王又开始胸闷了

吸取了上次经验
老王换了家“高级”的医院治病

医生
老先生,这个病俺没法治,你去郑州市中心医院呼吸科吧,那里的技术能治疗你这种气胸。
赶到郑州市中心医院
呼吸与危重症医学科一病区
科主任张华看了老王的胸部影像
那真是能用“惨不忍睹”来形容
正常人的肺部CT,肺部纹理有序、清晰

老王的肺部CT显示:右侧胸腔多发肺大疱,已经造成呼吸衰竭,必须立即治疗!
老先生,别担心,我们专治各种难治性气胸、持续性漏气、巨型肺大疱,您这种情况只需要做个微创手术…..

张华
我闷气的都躺不下了,能手术吗?
确实
从影像学检查来看
老王的肺部多发大疱
能有效呼吸的正常肺组织
已经极少
很难躺下接受手术
放心吧,老先生,我们有绝招!
张华
张华主任为老王评估后
立即安排术前检查
做好术前定位
医生余耀华在CT引导下进行
胸腔闭式引流+肺大疱疱内置管引流

老王“玩儿惊喜”
医生“玩儿魔术”
手术打开胸腔后,
确实让医生“惊喜粘连”


但这种情况
根本难不倒经验丰富的医生们
呼吸胸膜疾病介入小组
为老王进行了
“魔幻手术”——
“内科胸腔镜‘一镜加一针’
巨型肺大疱减容术”

术中无出血,术后不漏气,
老爷子胸闷、气喘明显缓解

老王这次“内科胸腔镜‘一镜加一针’巨型肺大疱减容术”是河南省首例!
这种治疗方式对不耐受外科干预的高龄、严重慢阻肺等高危患者的治疗意义相当于肺移植!
创伤更小、花费更少、
效果立竿见影!

郑州市中心医院
4分钟做完一台手术,主任又改绰号啦#疝气 #手术室日常
视频号
长按/扫码关注“郑州市中心医院”视频号

